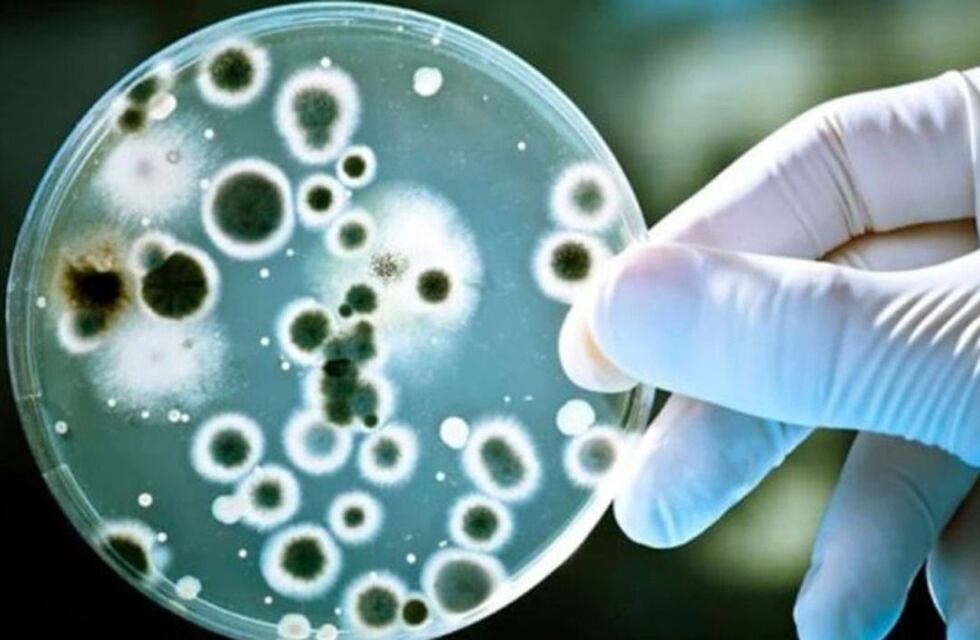
Qué es el Streptococcus pyogenes, la bacteria que afecta a casi 500 personas en el país

El Ministerio de Salud reportó 487 casos confirmados de la infección invasiva por Streptococcus pyogenes en todo el país. De los infectados, murieron 78 personas.
“Al 6 de noviembre de 2023, se notificaron al Sistema Nacional de Vigilancia de la Salud (SNVS 2.0) 487 casos de infección invasiva por Streptococcus pyogenes en todo el país, de los cuales 78 se trató de casos fallecidos”, señalaron desde la cartera.
Casi la mitad de los casos de Streptococcus pyogenes tenían menos de 16 años, (241 casos = 49,5%), mientras que el 38,5% de los casos fatales correspondieron a menores de 16 años, habiéndose distribuido el resto de los casos en todos los grupos de edad, agregó la información oficial.
El Streptococcus pyogenes es una bacteria Gram-positiva que es la causa bacteriana más frecuente de faringitis aguda e infecciones cutáneas como impétigo, celulitis y escarlatina.
Si bien la escarlatina no forma parte de los eventos de notificación obligatoria, los brotes de cualquier etiología sí son eventos notificables.
En ese contexto, en octubre de 2023 se notificó un brote de escarlatina en una Institución educativa en provincia de Santa Fe con 5 casos asociados, ninguno de los cuales requirió hospitalización y todos evolucionaron favorablemente.
A nivel internacional, a fines del año 2022 la Organización Mundial de la Salud (OMS) informó que al menos cinco Estados miembros de la región europea (Francia, Irlanda, los Países Bajos, Suecia y el Reino Unido de Gran Bretaña e Irlanda) habían reportado un aumento en el número de casos de enfermedad invasiva por estreptococo del grupo A (Streptococcus pyogenes) y que en algunos de esos países se observó un aumento en las muertes relacionadas a este evento.
El 19 de diciembre del mismo año, la OPS informó que en Uruguay hubo 21 casos con complicaciones debidas a la forma invasiva de enfermedades causadas por estreptococo del grupo A. Respecto a la evolución, ocho de los casos fallecieron, cuatro adultos (69 a 79 años) y cuatro niños de 1 a 7 años inmunocompetentes.
Cómo detectarlo
El Streptococcus del grupo A comúnmente origina distintas infecciones cutáneas como impétigo, celulitis, y escarlatina; sin embargo, en ocasiones, puede presentarse como una forma grave o enfermedad invasiva, que puede causar condiciones potencialmente mortales, siendo responsable de más de 500.000 muertes anuales en todo el mundo.
- El reservorio es el humano, formando parte de la microbiota normal. Las personas pueden ser portadoras asintomáticas.
- La transmisión ocurre por contacto directo con una herida en una persona infectada o a través de gotitas eliminadas con la tos, los estornudos o al hablar.
- El período de incubación para la enfermedad varía de acuerdo a la presentación clínica, entre 1 a 3 días.
- La faringitis se diagnostica mediante cultivos bacterianos y se trata con antibióticos. El tratamiento de elección es la penicilina.
Los síntomas de la faringitis son dolor de garganta; fiebre; cefaleas; dolor abdominal; náuseas y vómitos; enrojecimiento de faringe y amígdalas; mal aliento; ganglios aumentados de tamaño en el cuello.
En lo referido a la escarlatina los síntomas más frecuentes son garganta roja y adolorida; fiebre (38.3 °C o más); erupción color rojo con textura de papel de lija; piel de color rojo intenso en los pliegues de axila, codo e ingle; recubrimiento blancuzco sobre la lengua o el fondo de la garganta; lengua “aframbuesada”; dolor de cabeza; náuseas o vómitos; inflamación de los ganglios; dolores en el cuerpo.
Recomendaciones a tener en cuenta
Ante la presencia de algunos de estos síntomas es importante evitar la automedicación con antibióticos y realizar una consulta médica para tener diagnóstico oportuno, precisa la cartera sanitaria.
En el caso de recibir indicación médica de tratamiento antibiótico, es fundamental completar el esquema (cumplir con las dosis y horarios indicados, no acortar ni abandonar los tratamientos anticipadamente), ya que la utilización inadecuada de los antibióticos promueve la resistencia bacteriana, hecho que atenta contra su efectividad en el futuro.
Las personas enfermas deben evitar concurrir a lugares públicos (trabajo, escuela) y restringir los contactos hogareños. Además es de importancia lavarse las manos frecuentemente; no compartir objetos de uso personal (cubiertos, vasos, toallas, entre otros) y ventilar adecuadamente y de forma regular los ambientes.